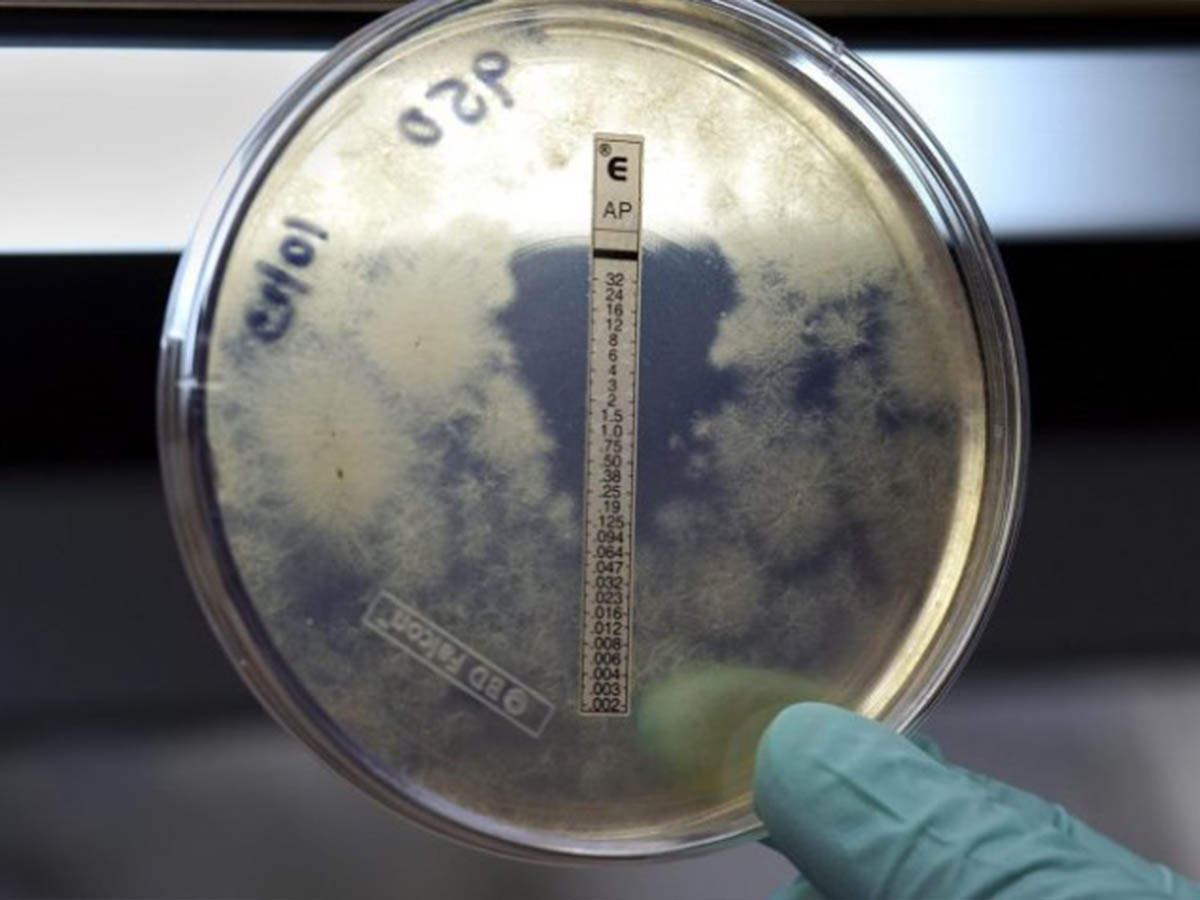

Idee
Idee
Malattie rare. Bartuli (Bambino Gesù): “Oltre a diagnosi e cure servono accoglienza e sostegno per bimbi e famiglie”
Oggi ricorre la Giornata mondiale delle malattie rare. In Italia i malati rari sono circa 2 milioni, di cui il 40% bambini. Due/tre anni il tempo medio per la diagnosi, ma un quarto di pazienti ne è ancora privo. Intervista con il responsabile di Malattie rare dell’ospedale pediatrico romano che ripercorre l’odissea delle famiglie. “La ricerca va avanti e l’industria farmaceutica è un solido alleato”, sostiene, “ma intanto ci dovrebbero essere più accoglienza e più giustizia per queste famiglie”